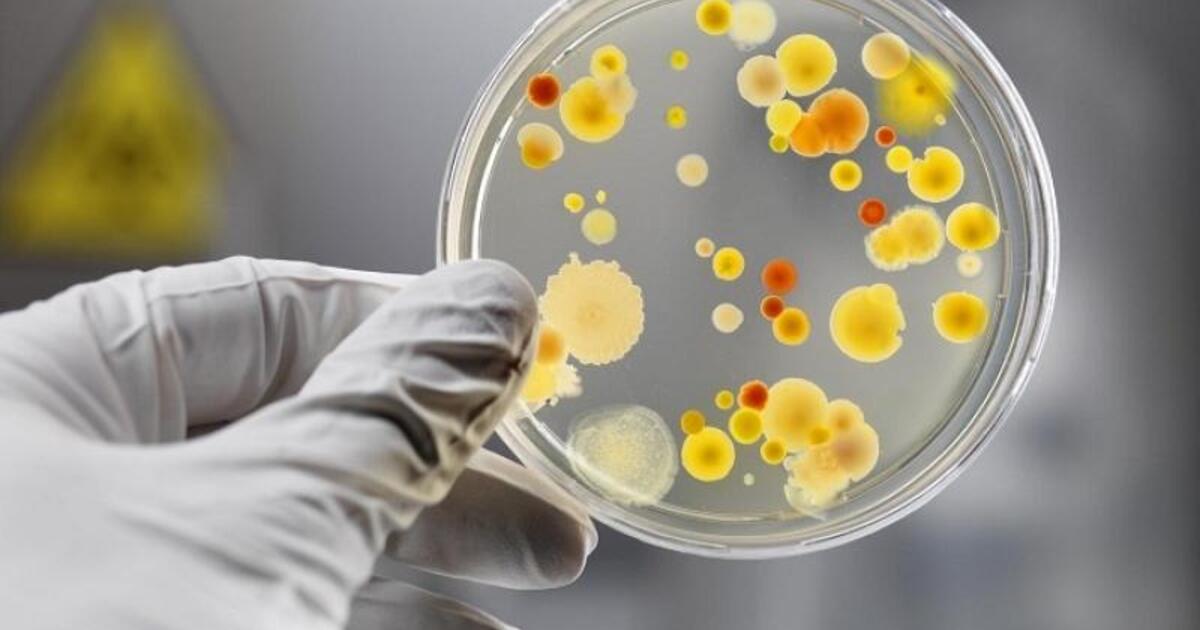
645aa9c42d185c63dd844e2594150a5978d5d3d7

Терапевтическое голодание оказалось полезным при кишечных инфекциях
В рамках научной работы специалисты проверяли влияние голодания и ограничения калорийности рациона на лабораторных мышах. Эксперимент предполагал заражение ими бактериями Salmonella с ограничением питания в течение двух дней до и после инфицирования. Отметим, что Salmonella у людей провоцируют инфекционные воспаления в желудочно-кишечном тракте.
В результате было установлено, что у грызунов при терапевтическом голодании снижалась интенсивность проявления бактериальной инфекции. Кроме того, было замечено, что у мышей исчезли повреждения в тканях кишечника. Это и позволило прийти к выводу о том, что терапевтическое голодание, совместно с ограничением калорийности, способствует скорейшему выздоровлению при кишечных инфекциях.
Материалы новостного характера нельзя приравнивать к назначению врача. Перед принятием решения посоветуйтесь со специалистом.
© Ferra.ru
